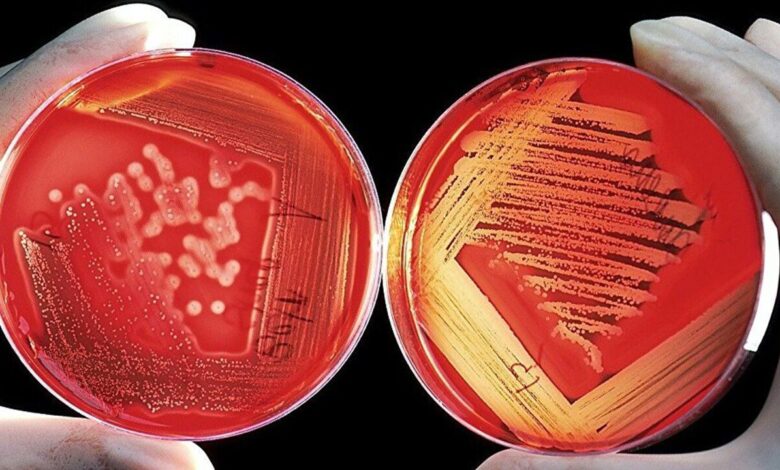

ابتكار إيراني في التشخيص المبكر للأمراض السرطانية

نجح تقنيو شركة نانوية إيرانية، بالاعتماد على قدرات الخبراء المحليين، في إنتاج علامات نانوية تشخيصية محليًا مما تلعب دورًا هامًا في الكشف السريع والدقيق عن أمراض مثل السرطان، التهابات الجهاز الهضمي، والحمل. وتُعد هذه الأطقم، عالية الجودة وأقل تكلفة من العينات الأجنبية، خطوة فعّالة نحو تحقيق الاكتفاء الذاتي في قطاع الصحة في البلاد، مع تقليل الاعتماد على الواردات.
تلعب التكنولوجيا الحيوية النانوية، باعتبارها أحد المحركات الرئيسية للتنمية المستدامة، دورا رئيسيًا في تعزيز الصحة العامة، تعزيز الأمن الغذائي، والحد من الملوثات البيئية، وزيادة الإنتاجية في القطاعات الصناعية.
ولا تحسن التكنولوجيا الحيوية النانوية جودة الحياة فحسب من خلال توفير منصات مبتكرة والاعتماد على المعرفة المحلية، بل يُمهّد الطريق أيضًا لاقتصاد قائم على المعرفة. وفي الجمهورية الإسلامية، تُشكّل الشركات القائمة على المعرفة موجةً جديدةً من الإنتاج المحلي من خلال تحديد الاحتياجات الاستراتيجية، ومن الأمثلة الناجحة على ذلك مجال أطقم التشخيص الطبي.
تمكّنت إحدى هذه الشركات، التي تُركّز على تطوير المنتجات الطبية الحيوية، وخاصةً أطقم التشخيص السريع، من اتخاذ خطواتٍ كبيرة نحو الاكتفاء الذاتي.
بدأ هذا المجمع القائم على المعرفة أنشطته في عام 2017 بتوجيه من “هادي باقري”، خريج التكنولوجيا الحيوية الطبية من جامعة تربية مدرس، وعلى مدار السنوات القليلة الماضية، وبالاستفادة من القدرات العلمية للخبراء الشباب في البلاد، نجح في إنتاج أكثر من 9 منتجات قائمة على المعرفة.
أشار “هادي باقري”، الرئيس التنفيذي للشركة هذه، إلى أهمية تقليل اعتماد البلاد على معدات التشخيص المستوردة، قائلاً:
“بناءً على دراسات السوق، يُنفق حوالي 10 ملايين دولار سنويًا على استيراد أطقم التشخيص السريع. وبهدف الحد من انخفاض قيمة العملة، بدأنا إنتاج هذه المنتجات على مراحل، واعتمدنا على الجودة العالية والأسعار التنافسية، وتمكنا من الاستحواذ على حصة سوقية تزيد عن 10% في أقل من عام.”
تُعدّ أطقم التشخيص السريع للنوبات القلبية أحد المنتجات الاستراتيجية للشركة، حيث تُحلّ محلّ واردات بملايين اليورو، وتُستخدم حاليًا في غرف الطوارئ في جميع أنحاء البلاد. وقد وصلت هذه الأطقم، التي يُستهلك منها أكثر من مليون قطعة في البلاد سنويًا، إلى مرحلة حالت دون دخول العينات الأجنبية إلى السوق.
وتشمل المنتجات البارزة الأخرى للشركة طقم فحص سرطان القولون، الذي طُوّر تماشيًا مع برنامج وزارة الصحة للوقاية من هذا المرض والكشف المبكر عنه، وقد أُجري أكثر من مليون ونصف مليون فحص في البلاد حتى الآن.
كما تشمل منتجات هذا المجمع أيضاً مجموعات الكشف عن عدوى المعدة (الملوية البوابية)، مجموعات الكشف عن عدوى الدم (بروكالسيتونين)، ومجموعات الكشف عن متلازمة القولون العصبي، وقد صُممت جميعها لتلبية الاحتياجات الفعلية للنظام الصحي الإيراني.
وفي مجال الابتكار، نجحت الشركة أيضاً في تطوير مجموعة غير جراحية للكشف عن سرطان القولون، والتي تُعدّ، وفقاً لمسؤولي الشركة، ثاني نموذج مُسجل في العالم، وهي على وشك دخول السوق الدولية بعد حصولها على براءة اختراع أمريكية.
يُعدّ هذا المنتج بديلاً عن طريقة تنظير القولون، ومن خلال الاستغناء عن الطرق الجراحية، يُسهّل تشخيص هذا السرطان ويُقلّل من تكلفته.
ومن المبادرات المهمة الأخرى للشركة إنتاج مجموعة الكشف عن المضادات الحيوية في الحليب. تُستخدَم هذه المجموعة في صناعة الألبان لمراقبة الجودة والسلامة، وقد فرضت حتى الآن ما يقرب من مليوني دولار من الواردات السنوية على البلاد. والآن، أصبح هذا المنتج متاحاً لشركات الألبان المحلية بعد حصوله على ترخيص من هيئة الطب البيطري.
وأضاف الرئيس التنفيذي للشركة،
وقال: “على الرغم من المنافسة الشرسة من المستوردين والتخفيضات المتعمدة في الأسعار في السوق، تمكنت الشركة من الحفاظ على حصتها السوقية، بل وزيادتها، من خلال خفض السعر النهائي لمنتجاتها بنسبة 45% دون المساس بالجودة.
وإضافةً إلى ذلك، يُعد تطوير خطوط الإنتاج، وتصنيع تقنية “التدفق الجانبي”، والتوطين الكامل للمعرفة التقنية من أهم عوامل نجاح الشركة”.
تنويه من موقع “بتوقيت بيروت”:
تم جلب هذا المحتوى بشكل آلي من المصدر:
arabicradio.net
بتاريخ: 2025-07-26 17:36:00.
الآراء والمعلومات الواردة في هذا المقال لا تعبر بالضرورة عن رأي موقع “بتوقيت بيروت”، والمسؤولية الكاملة تقع على عاتق المصدر الأصلي.
ملاحظة: قد يتم استخدام الترجمة الآلية في بعض الأحيان لتوفير هذا المحتوى.
ظهرت المقالة ابتكار إيراني في التشخيص المبكر للأمراض السرطانية أولاً على بتوقيت بيروت | اخبار لبنان والعالم لحظة بلحظة 24/24 تابعونا.




